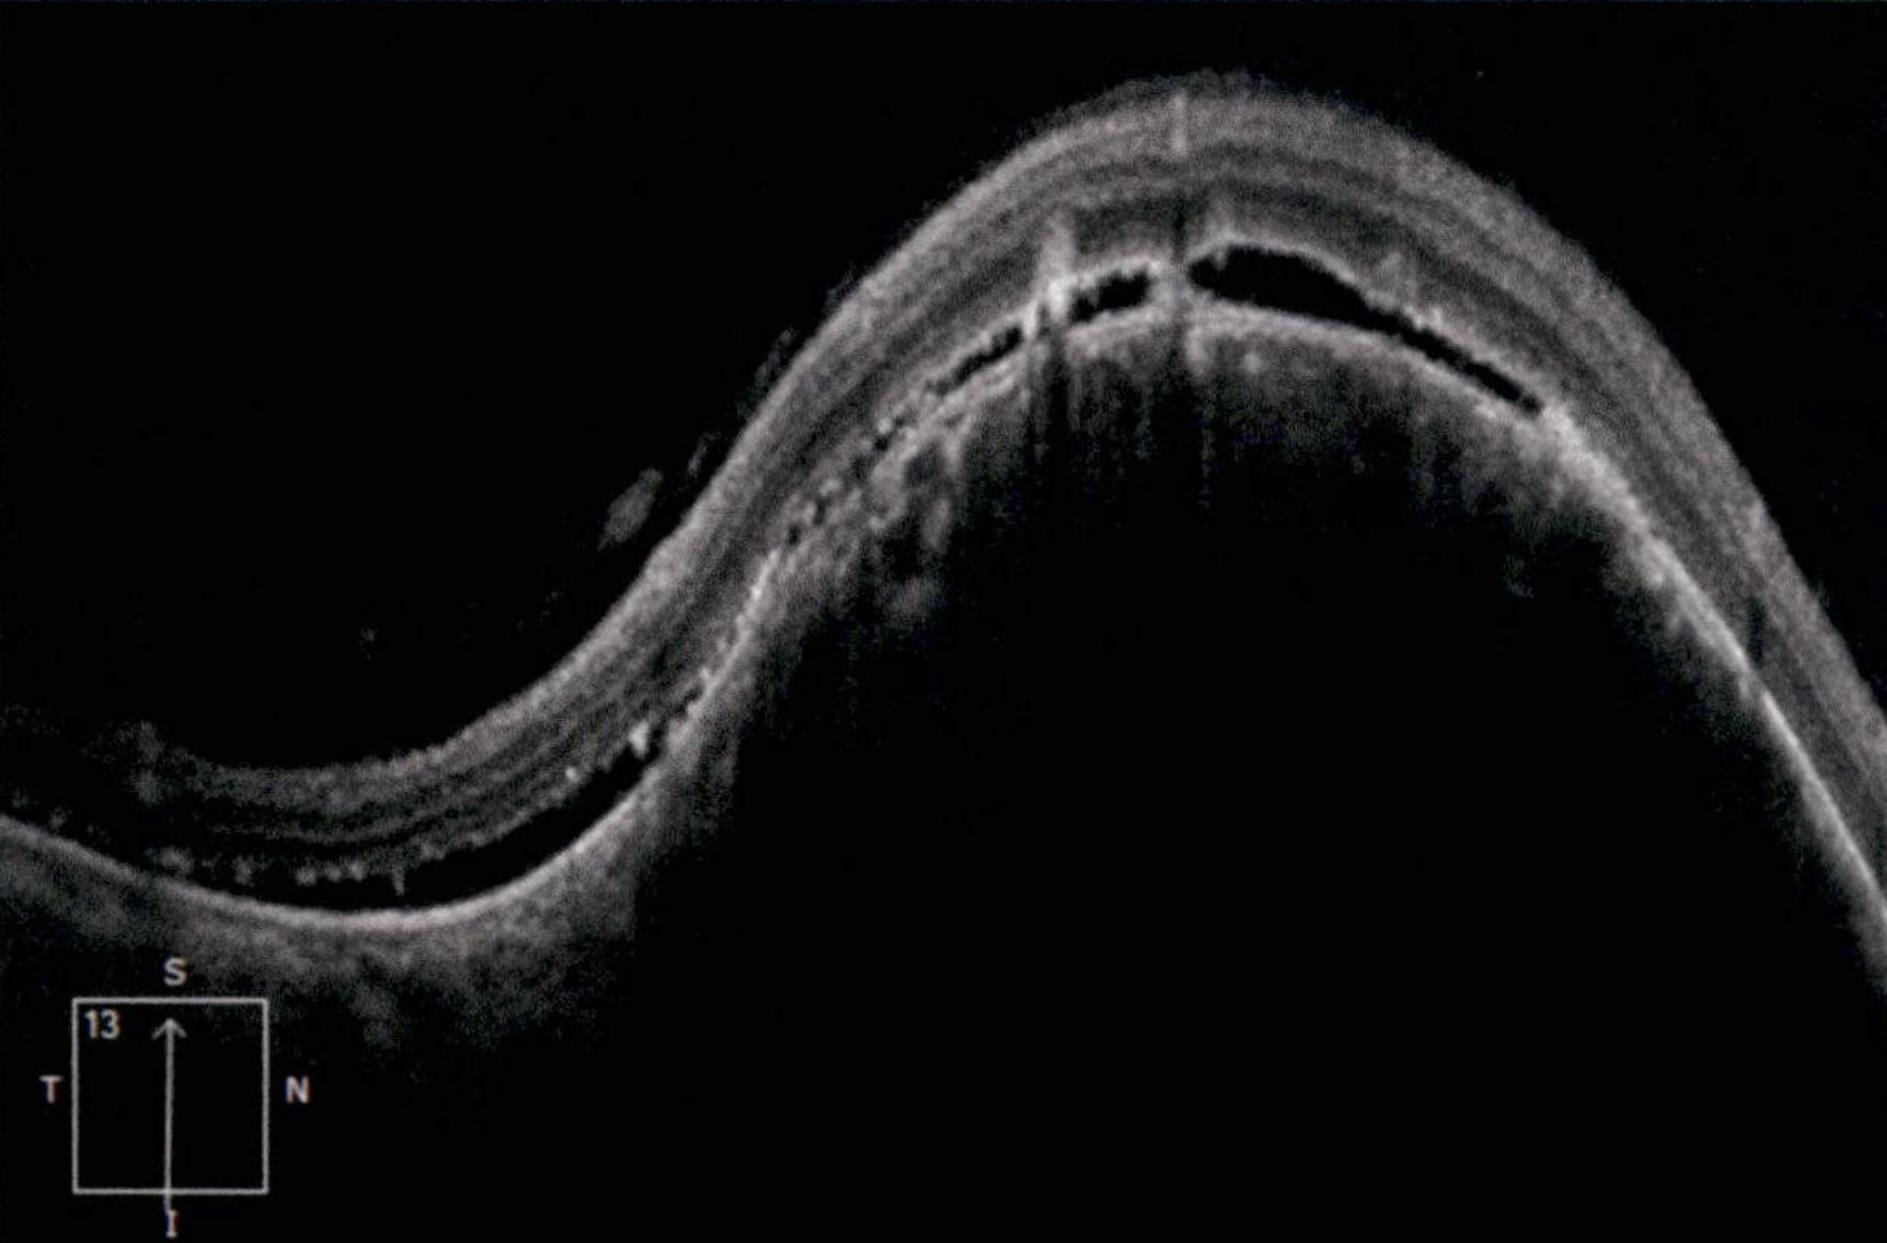

44YO Male patient with no comorbidities presented to the ER whose main complaint were floaters on his right eye. 20/20 Vision on Snellen Chart.
This case highlights an amelanotic melanoma, an atypical presentation of a choroidal melanoma lacking the characteristic pigmentation. These lesions can easily be mistaken for choroidal hemangiomas, metastases, or inflammatory masses. 🌹
Clinically, the lesion appears as a dome-shaped, yellowish subretinal mass, often associated with subretinal fluid, lipofuscin deposition, or retinal detachment. The absence of pigment can delay diagnosis, making multimodal imaging essential.
Amelanotic melanoma is a rare variant of uveal melanoma, accounting for only a minority of cases. Unlike pigmented melanomas, these lesions lack melanin, making them more challenging to detect on conventional color fundus imaging.

This FAF image reveals a hypoautofluorescent mass with areas of dense hyperautofluorescent stippling—a classic pattern suggestive of an amelanotic choroidal melanoma.

OCT image of the case with amelonitc choroidal melanoma
Credit: César Adrián Gómez Valdivia, MD
Instagram Account: @eyemissu2
Affiliation: Fundación Hospital Nuestra Señora de la Luz IAP

